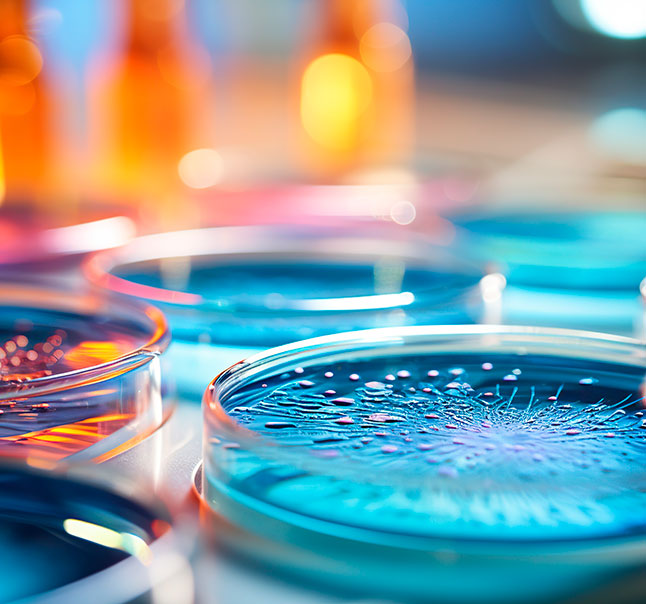
Servicio Autovacunas MPA

Servicios
Servicio analíticas
Colaboramos con los mejores laboratorios especializados con el fin de ofrecer a nuestros clientes un servicio de analítica de alta calidad. Las analíticas nos permiten en primer lugar determinar cuál es la situación inicial de su fábrica, materia prima o explotación y así recomendar la solución más adecuada para su caso. Posteriormente nos permiten monitorizar la eficacia del tratamiento propuesto y ajustarlo en caso de que sea necesario.

Servicio de autovacunas
Con el fin de aportar soluciones complementarias a nuestras soluciones nutricionales, ofrecemos un servicio de venta de autovacunas.
Las autovacunas son un medicamento inmunológico individualizado, elaborado a partir de patógenos y antígenos no virales, obtenidos de un animal o animales de una misma explotación, inactivados y destinado para el tratamiento de dicho animal o explotación.
Las autovacunas están indicadas para prevenir y tratar aquellas enfermedades bacterianas para las que no existen vacunas comerciales o estas no son eficaces, contribuyendo a la reducción de uso de tratamientos antibióticos.
Están diseñadas exclusivamente para cada explotación y pueden incluir varias cepas. Pueden ser una solución en casos de inmunidad específica de serotipo, ya que incluyen los serotipos presentes a la explotación a las que van destinadas. Para su producción se requiere una receta veterinaria excepcional.
Consulta con nuestro equipo técnico para determinar qué apoyo ofrecemos en tu localización a través del formulario de contacto.






